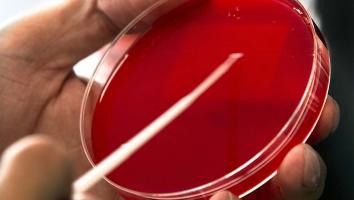
de mrsa-bacterie

Hoelang werken antibiotica nog?

Hoelang werken antibiotica nog?
Laatste update: 25-08-2025
Antibiotica zijn hét geneesmiddel van de vorige eeuw. Dankzij dit middel zijn veel ziektes niet langer dodelijk. Het middel werkt ook nog eens snel en is goedkoop. Maar er is een probleem: door veelvuldig gebruik van antibiotica worden bacteriën resistent en dat is een serieuze bedreiging voor onze gezondheid.
Redacteur: Femke van der Laan
Wat zijn bacteriën?
Bacteriën zijn eencellige micro-organismen: ze zijn zo klein dat ze alleen onder een microscoop zichtbaar zijn. Ieder mens draagt meer dan honderdduizend miljard bacteriën bij zich in veel verschillende soorten. Het overgrote deel van deze bacteriën zorgt dat we gezond blijven. Zo helpen de bacteriën in de darmen bij het goed verteren van voedsel en die op de huid weren zich tegen schadelijke invloeden van buitenaf. Maar er zijn ook bacteriën die infecties kunnen veroorzaken. Die komen binnen via ons voedsel, omdat we ze inademen of bijvoorbeeld door een wond. Bacteriën kunnen razendsnel groeien en zichzelf delen. Als ons lichaam niet genoeg weerstand heeft om zo'n infectie te bestrijden dan kan antibiotica daarbij helpen.
Wat zijn bacteriën? Martin Blaser, auteur van De beestjes in ons, legt uit waarom zelfs schadelijke bacteriën goed voor ons kunnen zijn. De hele aflevering zien? Kijk op NPO Start.
Wat zijn antibiotica?
Letterlijk betekent antibioticum: tegen het leven. In dit geval gaat het om het leven van bacteriën die ziekten veroorzaken. Die bacteriën moeten worden uitgeschakeld en dat is precies wat antibiotica doen: het elimineren van ziekmakende bacteriën. Grofweg zijn er twee soorten antibiotica: de groep die bacteriën doodt en de groep die bacterieremmend werkt. Wat de eerste groep doet is duidelijk: de bacteriën gaan er zonder pardon aan. Wat die bacterieremmende groep betreft: die zorgen ervoor dat bacteriën zich minder goed vermenigvuldigen. Het lichaam krijgt daardoor de kans om te herstellen en vervolgens kan het eigen immuunsysteem de bacteriën uit de weg ruimen.
Een arts schrijft alleen antibiotica voor als het echt nodig is. Antibiotica kunnen namelijk ook bijwerkingen hebben. Zo zijn er antibiotica die alle bacteriën doden, dus ook de nuttige. Hierdoor kan iemand bijvoorbeeld last krijgen van diarree of een schimmelinfectie. Antibiotica voorschrijven aan patiënten die het niet nodig hebben, werkt bovendien antibioticaresistentie in de hand.
Binnen twee weken is een groep e.coli-bacteriën bestand tegen 1000 keer de normale dosis antibiotica.
Hoe zijn antibiotica ontdekt?
Antibiotica zijn ontdekt door Alexander Fleming (1881-1955). Deze Brit was arts en microbioloog. Hij hield zich onder andere bezig met de behandeling van syfilis, een seksueel overdraagbare aandoening die veroorzaakt wordt door een bacterie. In 1928 heeft Fleming een aantal glazen schaaltjes met bacteriekolonies – stafylokokken in dit geval – in zijn laboratorium staan. Zelf gaat hij er een paar dagen tussenuit. Als Fleming terugkomt in zijn lab, merkt hij dat een van zijn bacterieculturen bezoek heeft gekregen van een zogeheten penseelschimmel. Hij vermoedt dat deze schimmel is binnen komen waaien vanuit een naburig laboratorium. In het glazen schaaltje zijn rondom de verdwaalde penseelschimmel Flemings bacteriën verdwenen.
Eigenlijk kan zijn bacteriekolonie rechtstreeks de prullenbak in, maar Fleming realiseert zich dat hier misschien wel iets bijzonders aan de hand is. Hij weet de stof die de penseelschimmel afscheidt – en die inderdaad bacteriën blijkt te doden – te isoleren en noemt het penicilline. Fleming schrijft er nog een wetenschappelijk artikel over en dat was dat: het is in die jaren bijzonder ingewikkeld om penicilline uit penseelschimmel te verkrijgen, zodat de wetenschap Flemings ontdekking verder links laat liggen.
Tot tien jaar later de Tweede Wereldoorlog uitbreekt. Er is dan – onder andere vanwege de vele oorlogsgewonden – zo'n behoefte aan een middel om infectieziektes te bestrijden dat Flemings ontdekking weer uit de kast wordt getrokken. Inmiddels zijn de instrumenten ook verbeterd en Ernst Boris Chain (1906-1979) en Howard Florey (1898-1968), twee wetenschappers uit Oxford, vinden wél een manier om op grotere schaal penicilline uit schimmels te verkrijgen en er een medicijn van te maken. Door de inzet van penicilline zijn infectieziektes zoals longontsteking, blaasontsteking of geslachtsziekten vanaf dat moment niet langer dodelijk. De drie heren Fleming, Chain en Florey krijgen in 1945 de Nobelprijs voor hun werk. Inmiddels bestaan er naast penicilline andere soorten antibiotica, zoals tetracyclines en macroliden, die allemaal tegen verschillende soorten bacteriën werken.
"Ik was enorm dankbaar dat ik hieraan had mogen meewerken."
Wat is antibioticaresistentie?
Antibioticaresistentie betekent dat bepaalde bacteriën niet langer gevoelig zijn voor bepaalde antibiotica. Ze hebben een manier gevonden om zich te beschermen tegen het antibioticum en laten zich door deze medicijnen niet langer remmen of doden. Als de niet-resistente bacteriën wel het loodje hebben gelegd door een bepaald antibioticum, geeft dat alle ruimte aan de resistente bacteriën om te groeien en weer een nieuwe infectie te veroorzaken. Deze infectie is dan al iets moeilijker te behandelen: het eerder gebruikte antibioticum werkt immers niet meer. Dan wordt er dus gekozen voor een ander antibioticum, maar op den duur zullen er ook bacteriën ontstaan die resistent zijn voor dat volgende antibioticum. Zo blijven er steeds minder antibiotica over die nog effect hebben op de bacteriën. Dat kan er uiteindelijk toe leiden dat er geen enkel antibioticum meer effectief is en we in de toekomst wellicht weer overlijden aan iets simpels als een blaasontsteking.
Door vaak gebruik te maken van hetzelfde antibioticum wordt de kans op resistentie steeds groter: de bacteriën krijgen als het ware de kans een wapen te vinden waarmee ze zich tegen het medicijn kunnen verdedigen. Ook verkeerd antibioticagebruik kan leiden tot resistentie. Als een patiënt zijn kuur niet afmaakt, en er bevinden zich nog ziekmakende bacteriën in het lichaam, dan zijn dat vaak net de bacteriën die minder gevoelig zijn voor het medicijn. Die krijgen dan de kans om te hergroeperen en te herbewapenen.
De Kennis van Nu legt uit wat resistente bacteriën en hoogspringen met elkaar te maken hebben. Resistente bacteriën zijn als de Fosbury Flop.
De ontdekker van de penicilline waarschuwde al voor antibioticaresistentie. Op 11 december 1945, aan het einde van zijn Nobelprijs-speech, zegt Fleming: “Er komt wellicht een tijd dat penicilline gewoon in de winkel gekocht kan worden. Dat brengt het gevaar met zich mee dat een onwetend mens zichzelf makkelijk een onderdosis kan toedienen. En doordat hij daarmee de bacteriën in zijn lichaam in aanraking brengt met niet-dodelijke hoeveelheden van het medicijn, kunnen die bacteriën resistent worden.” Hij illustreert zijn betoog met een verzonnen voorbeeld: “Stel dat meneer X een zere keel heeft. Hij gaat naar de apotheek en koopt penicilline. Hij neemt er zoveel van in dat het niet genoeg is om de streptokokken te doden, maar wel genoeg om de streptokokken te leren hoe ze zich tegen penicilline moeten verdedigen. Vervolgens infecteert hij zijn vrouw met deze resistente bacteriën. Mevrouw X krijgt griep en wordt behandeld met penicilline. Omdat de streptokokken resistent zijn geworden, slaat de behandeling niet aan. Mevrouw X gaat dood. Wie heeft er schuld aan haar dood? Meneer X, omdat hij slordig is omgesprongen met de penicilline en daardoor de aard van de bacteriën heeft veranderd. Moraal: als je penicilline gebruikt, gebruik dan genoeg.”

Komt antibioticaresistentie ook bij dieren voor?
Antibiotica worden ook bij dieren gebruikt om bacteriële infecties te bestrijden. Dat kan gaan om individuele dieren, maar in de veehouderij komt het ook voor dat vanwege een paar zieke dieren een hele stal tegelijk aan de antibiotica gaat. En tot 2006 werd er zelfs nog massaler antibiotica toegediend: tot die tijd werden antibiotica door het voer gemengd om de groei van dieren te bevorderen. In Nederland hoef je nu niet bang te zijn dat je veel antibiotica binnenkrijgt via vlees, melk of eieren. Er is wettelijk vastgesteld hoeveel antibiotica er in voedsel mag zitten en dat is een minieme hoeveelheid. Ook mogen dieren die behandeld zijn met antibiotica niet geslacht worden. Tegen de tijd dat dat wel weer is toegestaan zijn de antibiotica zo goed als verdwenen.
Het op grote schaal toedienen van antibiotica bij dieren zorgt wel voor een ander probleem: resistente bacteriën. En die bacteriën kunnen mensen binnenkrijgen via bijvoorbeeld (ongaar) vlees. ESBL (Extended Spectrum Beta-Lactamase) is hier een voorbeeld van. ESBL zit vaak in kippenvlees. Geschat wordt dat meer dan een miljoen mensen in Nederland besmet zijn met ESBL. Voor gezonde mensen geen enkel probleem: zij dragen ESBL met zich mee zonder er ziek van te worden. Mensen met een verminderde weerstand kunnen er wel infecties door oplopen. Zeker in ziekenhuizen – waar natuurlijk veel mensen met een verminderde weerstand bij elkaar zijn – zijn ESBL-infecties een grote zorg. En antibiotica helpen niet langer.
Meer dan een miljoen Nederlanders hebben de ESBL-bacterie onder de leden.
Een ander voorbeeld van zo’n multiresistente bacterie is MRSA (Meticilline Resistente Staphylococcus Aureus). Deze is vaak terug te vinden bij varkens en kalveren. Het RIVM becijfert dat zeventig tot negentig procent van de varkens- en vleeskalverhouderijen in Nederland is besmet met MRSA. Ook MRSA zorgt voor epidemieën in ziekenhuizen, daarom wordt MRSA ook wel de ziekenhuisbacterie genoemd.
Komt antibioticaresistentie alleen in Nederland voor?
Als je naar andere landen kijkt is de resistentie in Nederland nog behoorlijk laag. In Europa gaan er elk jaar zeker 25.000 mensen dood door infecties die ontstaan door resistente bacteriën.
Antibioticaresistentie is een wereldwijd probleem.
De al eerder genoemde MRSA-bacterie komt veelvuldig voor in buitenlandse ziekenhuizen. Vandaar ook dat mensen die in het buitenland in een ziekenhuis verpleegd zijn in Nederland apart van de andere patiënten worden geplaatst.
In de zuidelijke landen van Europa wordt er drie keer zo vaak antibiotica voorgeschreven als in Nederland. Er zijn ook Europese landen waar je zelfs geen recept van de dokter nodig hebt om aan een antibioticakuurtje te komen. In die landen wordt dus te makkelijk omgesprongen met het medicijn. Buiten Europa is het probleem nog groter. In ontwikkelingslanden laat de kwaliteit van antibiotica regelmatig te wensen over. En omdat antibiotica daar duur zijn kiezen patiënten er vaak voor hun kuur niet helemaal af te maken. In een land als China zijn de cijfers ook verontrustend. Daar werd in 2013 zo’n 162.000 ton antibiotica gebruikt: 78.000 ton door mensen en 84.000 ton door dieren. Ook loost de farmaceutische industrie in China grote hoeveelheden antibiotica op het oppervlaktewater zoals rivieren. Bacteriën, resistent of niet, houden zich niet aan landsgrenzen. Antibioticaresistentie is dus een wereldwijd probleem.
Hoe lang werken antibiotica nog?
Het doemscenario is natuurlijk dat op een gegeven moment ziekmakende bacteriën resistent zijn tegen alle vormen van antibiotica. Of we ooit daadwerkelijk op dat punt gaan belanden is niet te voorspellen. En dat moment wordt gelukkig ook niet lijdzaam afgewacht. Het is zaak dat de huidige antibiotica werkzaam blijven en dat resistentieverspreiding wordt voorkomen. Er wordt daarom, bijvoorbeeld door de Wereldgezondheidsorganisatie, veel tijd en geld gestoken in preventie van antibioticamisbruik en voorlichting over juist antibioticagebruik.
Tegelijkertijd wordt er gezocht naar nieuwe vormen van antibiotica. De farmaceutische industrie staat wat dat betreft niet vooraan: onderzoek is duur en antibiotica zijn goedkoop, dus leveren ze de medicijnfabrikanten te weinig op. Gelukkig zijn er wel wetenschappers die zich bezighouden met de zoektocht naar oplossingen voor het antibioticaprobleem.
Vier onderzoekers zoeken naar wegen om de bacterie een stap voor te blijven. De hele aflevering zien? Kijk op NPO Start.
Er wordt niet alleen gezocht naar nieuwe vormen van antibiotica, men onderzoekt ook oude vormen van antibiotica. Zo wordt er gekeken naar het gebruik van bacteriofagen.
Bacteriofagen, of kortweg fagen, zijn virussen die bacteriën gericht kunnen doden. De naam komt van het Griekse phagein: ‘eten’. Een bacteriëneter dus. Elke type faag richt zich op één soort bacterie. In de kop van de faag zit het DNA dat door zijn staart in een bacterie geïnjecteerd kan worden. Dat DNA kopieert zichzelf waardoor er in de bacterie allemaal nieuwe fagen ontstaan. Uit dat DNA komt vervolgens een eiwit dat ervoor zorgt dat de wand van de bacterie openbarst. De bacteriofagen gaan vervolgens door naar de volgende bacterie.
De bacteriën proberen zich ondertussen te wapenen tegen de bacteriofagen. Net zoals ze tegen antibiotica zouden doen, door zichzelf te veranderen. Maar wat antibiotica niet kunnen, kunnen de fagen wel: zij passen zich op hun beurt ook razendsnel aan, zodat ze alsnog de bacteriën kunnen doden.

Bacteriofagen huizen op plekken waar veel bacteriën aanwezig zijn. Dat kan bijvoorbeeld in de grond zijn, maar ook op je handen of op je mobiel. Ze worden – rond dezelfde tijd dat penicilline wordt ontdekt – voor het eerst gezien in monsters van niet zo schoon rivierwater. In West-Europa gaat de voorkeur al snel uit naar antibiotica. Die medicijnen kunnen verschillende bacteriën tegelijkertijd doden terwijl elke bacteriofaag maar een specifieke soort bacterie als doelwit heeft.
In de voormalige Sovjet-Unie is de behandeling met bacteriofagen en het onderzoek ernaar ondertussen gewoon doorgegaan. Onder meer omdat antibiotica daar moeilijk te verkrijgen waren. In ziekenhuizen in bijvoorbeeld Georgië kun je je nog steeds laten behandelen met fagen. Fagenpillen zijn er vrij verkrijgbaar in de plaatselijke apotheek. De bijwerkingen van zo’n fagenbehandeling zijn minimaal: de bacteriofagen richten zich immers op één bacterie en laten de andere – goede – bacteriën met rust. Geen diarree of schimmelinfectie dus. En zoals gezegd geen resistentie. Logisch dat de Westerse wetenschap zich inmiddels ook op bacteriofagen richt. Maar het zal nog wel even duren voor we in West-Europa een fagencocktail kunnen nemen. Het wachten is onder andere op het moment dat ze getest zijn volgens EU-richtlijnen en daar gaan zeker nog jaren overheen.
Bepaalde antibiotica hebben effect op de darmwand en de darmflora van dieren. Ze zorgen ervoor dat het voedsel daar beter wordt opgenomen. Op die manier kunnen dieren met dezelfde hoeveelheid en soort voedsel sneller groeien. Deze zogeheten groeibevorderaars zijn in Nederland inmiddels verboden.
In het kort
Bacteriën zijn eencellige micro-organismen. De meeste soorten bacteriën zorgen dat we gezond blijven, sommige soorten maken ons ziek. Antibiotica elimineren ziekmakende bacteriën.
Antibiotica zijn bij toeval ontdekt door de Brits arts en microbioloog Alexander Fleming (1881-1955).
Antibioticaresistentie betekent dat bepaalde bacteriën niet langer gevoelig zijn voor bepaalde antibiotica. Ze hebben een manier gevonden om zich te beschermen tegen het medicijn. Dit kan ertoe leiden dat op een gegeven moment geen enkel antibioticum meer effectief is.
Resistentie is een wereldwijd probleem en komt zowel bij mens als dier voor.
De wetenschap is bezig met een zoektocht naar nieuwe – en oude – vormen van antibiotica.
En je weet het!
Anderen het laten weten?
